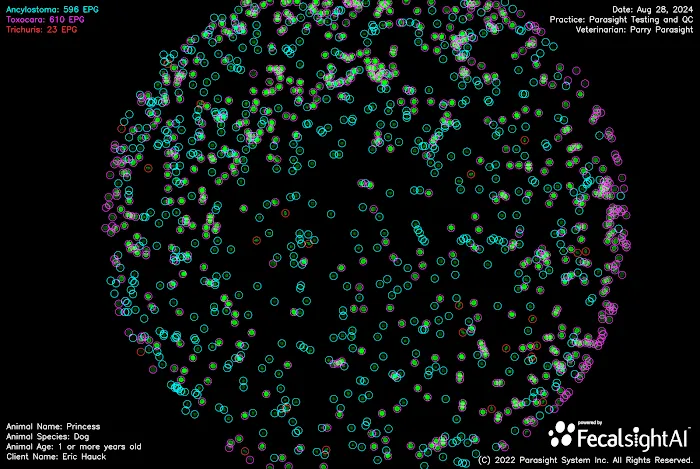

Parasight System Inc Introduce
For individuals and agricultural professionals across Kentucky, maintaining the optimal health of diverse animal populations—from companion pets to valuable small ruminants and poultry—requires access to accurate and efficient veterinary diagnostics. Parasight System Inc, located right here in Lexington, stands at the forefront of this need, though it operates in a unique capacity. It is not a traditional walk-in veterinary clinic, but rather a pioneering animal health technology company that significantly enhances the quality of care provided by veterinarians throughout the region and beyond.
Parasight System Inc specializes in developing and manufacturing advanced veterinary diagnostic analyzers. Their core mission is to revolutionize veterinary medicine by improving the health of animals and the operational efficiency of veterinary practices. They achieve this by replacing manual, time-consuming, and often subjective diagnostic methods—like traditional fecal exams—with cutting-edge, AI-powered technology.
Their proprietary technology, including the All-in-One (AIO) diagnostic analyzer, combines antigen-based fluorescence detection with advanced deep-learning AI image recognition. This system delivers results that can be four to ten times more precise than conventional methods. For Kentucky pet owners, farmers, and veterinarians, this means faster, more accurate diagnoses, leading to timely and effective treatment for a wide variety of animals, including companion pets and various livestock. Their innovations are critical in the ongoing fight against issues like anthelmintic resistance, which is a significant concern for both livestock and equine industries in the Bluegrass State.
While clients will not typically bring their pets directly to the N Limestone address for a routine check-up, this location is the corporate and innovation hub where the technology designed to "Help Vets Help Pets" is developed, refined, and distributed. The ultimate beneficiaries are the diverse animal populations of Kentucky—from the dogs and cats in our homes to the small ruminants and chickens on local farms.
Parasight System Inc is strategically located in Lexington, KY, a city known for its connection to animal health and agricultural technology. The facility operates as a business and innovation center, supporting veterinary practices across Kentucky and the country.
Address: 1532 N Limestone, Lexington, KY 40505, USA
Although it is primarily a corporate and R&D location, the facility is committed to business accessibility, offering features that ensure smooth operations and professional interaction with partners and employees:
- The facility maintains professional amenities, including a clean Restroom.
- It offers Wheelchair accessible entrance, Wheelchair accessible parking lot, and a Wheelchair accessible restroom.
As a technology provider, the core interaction with the Kentucky community involves partnering with local veterinary clinics and researchers. The information provided about "Appointments recommended" pertains to scheduling demonstrations, meetings, or partnership discussions rather than pet owner visits.
Parasight System Inc's technology is designed to support the diagnostic needs for a wide array of animal species, reflecting the diverse animal population of the Kentucky region. Their diagnostic systems are validated for use with samples from numerous animals, ensuring precision in detecting and quantifying parasites and pathogens:
- Companion Animals: Diagnostics for Small Animals, specifically Cats and Dogs, including high-sensitivity fecal egg counts for hookworms, roundworms, whipworms, and coccidia.
- Small Ruminants: Advanced testing for Goats and Sheep, crucial for managing gastrointestinal parasites in farm and agricultural settings to combat drug resistance.
- Poultry: Diagnostic solutions adaptable for Chickens and other backyard or commercial poultry, assisting with flock health management.
- Comprehensive Pathogen Detection: Systems capable of testing fecal, mucus, and blood samples for a wide array of pathogens, including heartworm, Lyme disease, Giardia, and various bacterial and viral infections.
- Quantitative Results: Providing quantitative Fecal Egg Counts (FECs) that are significantly more accurate than traditional methods, essential for targeted deworming protocols.
The company’s focus on multi-species support makes their technology highly relevant for the mixed animal practices prevalent throughout Kentucky.
The innovation developed by Parasight System Inc represents a significant leap forward in animal healthcare technology, offering numerous benefits to Kentucky veterinary practices and, subsequently, the animals they treat:
- AI-Powered Automation: The use of deep-learning Artificial Intelligence streamlines the diagnostic process, eliminating subjective interpretation and human error associated with manual fecal exams.
- Fluorescence Detection: This patented chemical treatment and imaging method highlights parasite ova with unmatched contrast, making the system significantly more sensitive than conventional microscopy.
- Rapid, Real-Time Results: The All-in-One analyzer is capable of providing accurate, quantitative results in minutes, enabling veterinarians to make on-the-spot treatment decisions during a pet's visit.
- Multi-Species Versatility: The system is designed to provide diagnostic support for the broad range of animals found in Kentucky, from companion pets to Small Ruminants and Chickens, making it highly versatile for mixed-animal practices.
- High Accuracy and Precision: Independent studies have shown their diagnostic results to be highly correlated with gold-standard research methods and significantly more sensitive than other commercially available point-of-care systems.
- Combating Drug Resistance: By providing precise quantitative counts, the technology supports targeted parasite control and Fecal Egg Count Reduction Tests (FECRTs), which are vital tools in the global effort to reduce unnecessary dewormer use and combat drug resistance.
For veterinarians, researchers, and partners in Kentucky interested in the cutting-edge diagnostic technology offered by Parasight System Inc, please use the following contact details. Pet owners should contact their local veterinary clinic to inquire if they utilize the Parasight System.
Primary Contact Phone: (833) 233-7278 (Toll-Free)
Mobile Phone (Direct): +1 833-233-7278
Corporate Address: 1532 N Limestone, Lexington, KY 40505, USA
For veterinary professionals and, by extension, informed pet and livestock owners in Kentucky, choosing to utilize the technology developed by Parasight System Inc means choosing the future of animal health. While clients do not visit this location for a check-up, the choice to support or utilize this Lexington-based innovation is a choice for unparalleled diagnostic accuracy and efficiency. The integration of advanced AI and superior fluorescence technology for species including Small Animals, Dogs, Cats, Goats, Sheep, and Chickens provides a level of certainty and speed unavailable with older methods.
The value proposition is clear: the technology significantly reduces the risk of missed diagnoses, ensures that parasite treatments are precise and necessary, and directly aids in the vital effort to slow the progression of drug resistance across animal populations in Kentucky. By leading the charge in developing sophisticated, user-friendly, and validated diagnostic equipment from their Lexington hub, Parasight System Inc is not just a local business; it is a critical partner in elevating the standard of Animal Care for all creatures in the Bluegrass State.
Parasight System Inc Services
Veterinarian
- Small Animals
- Dogs
- Cats
- Small Ruminants
- Chickens
- Goats
- Sheep
Parasight System Inc Photos

Parasight System Inc Location
Parasight System Inc
1532 N Limestone, Lexington, KY 40505, USA
Parasight System Inc Reviews
More Pet Store Near Me
North Lexington Veterinary Clinic4.0 (119 reviews)1402 N Broadway, Lexington, KY 40505, USA
Noah's Ark Animal Hospital4.0 (163 reviews)1782 Bryan Station Rd, Lexington, KY 40505, USA
Eastland Animal Clinic4.0 (236 reviews)1301 Eastland Dr, Lexington, KY 40505, USA
All Creatures Great & Small Animal Hospital4.0 (118 reviews)1020 Industry Rd #32, Lexington, KY 40505, USA
VIP Petcare Vaccination Clinic0.0 (0 reviews)1307 Winchester Rd, Lexington, KY 40505, USA
Bluegrass Veterinary Specialists + Animal Emergency4.0 (696 reviews)1591 Winchester Rd #106, Lexington, KY 40505, USA
Equine Medical Associates, PSC4.0 (13 reviews)996 Nandino Blvd, Lexington, KY 40511, USA
Cummins John R DVM4.0 (10 reviews)780 Faulkner Ave, Lexington, KY 40505, USA
Chevy Chase Animal Clinic4.0 (788 reviews)600 Euclid Ave, Lexington, KY 40502, USA
Uptown Hounds: Johnson Mindy DVM4.0 (12 reviews)466 Angliana Ave, Lexington, KY 40508, USA
Veterinary Wellness Center4.0 (124 reviews)466 Angliana Ave, Lexington, KY 40508, USA
Henry Schein Animal Health4.0 (13 reviews)920 Citation Blvd, Lexington, KY 40511, USA
Categories
Top Visited Sites
1214 Central Store0.0 (0 reviews)
Burlington Pet Hospital4.0 (118 reviews)
ArkVets4.0 (426 reviews)
Hartzell Veterinary Service: Charles W. Hartzell, DVM and Sue Ann Hartzell, DVM4.0 (105 reviews)
Noah's Ark Animal Hospital4.0 (163 reviews)
Jasper Pet Clinic4.0 (285 reviews)Trending Pet Health Blogs Posts
Transitioning Training Methods as Pet Ages: Adapting Techniques for Senior Pets
How to Read & Understand Pet Nutrition Labels for Your Pet's Health
How to Choose the Right Pet Supplement Brand: Essential Tips for Pet Owners
How Much Should You Feed Your Pet? Portion Guide by Age & Breed
How to Create a Pet Health Journal: Metrics to Track for Better Pet Care
What Breed-Specific Health Issues You Should Be Aware Of
